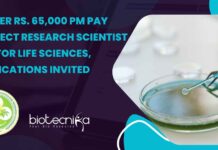
PGIMER Rs. 65,000 pm Pay Project Research Scientist Job For Life Sciences, Applications Invited PGIMER Project Research Scientist Job

CSIR-CDRI Bioinformatics Project Jobs For MSc & PhD – Attend Walk-In Interview
CSIR-CDRI Bioinformatics Project Jobs For MSc & PhD - Attend Walk-In Interview
CSIR-CDRI Bioinformatics Project Jobs For MSc & PhD - Attend Walk-In Interview. Interested...
Clarivate Content Analyst Job For Life Science, Apply Now
Clarivate Content Analyst Job For Life Science, Apply Now
STEM Content Analyst - Pharmacovigilance
Location: Tamil Nadu, India
Category: Life Sciences & Healthcare
Remote: On-Site
Job ID: JREQ130434
Posted Date:...
Novonesis Regulatory Affairs Associate Job For Life Sciences, Apply Online
Novonesis Regulatory Affairs Associate Job For Life Sciences, Apply Online
Junior Regulatory Affairs Associate
Remote type: Hybrid
Locations: Bangalore
Time type: Full time
Posted on: Posted Today
Time left to...
Freshers Reliance Life Sciences Job Opening For Biotech, Apply Online
Freshers Biotech Jobs at Reliance Life Sciences, Apply Online
Job Details
Young Professionals
Posted Date: 21 Jan 2025
Function/Business Area: Life Sciences
Location: DALC - Navi Mumbai
Job Responsibilities:
1)...
DRDO-DRDE Research Job With Rs. 67,000 pm Pay – Life Sciences Attend Walk-In
DRDO-DRDE Research Job With Rs. 67,000 pm Pay - Life Sciences Attend Walk-In
DRDO
DEFENCE RESEARCH AND DEVELOPMENT ESTABLISHMENT (DRDE) Defence Research and Development Organization (DRDO)...
Field Service Engineer Role For Life Sciences at Agilent Solutions, Apply Online
Field Service Engineer Role For Life Sciences at Agilent Solutions, Apply Online
Field Service Engineer
India-Mumbai-Exec Suite
India-Ahmedabad
India-Remote Location-Pune
Time type: Full time
Posted on: Posted Today
Job Requisition ID:...
Natus Medical Market Quality Assurance Research Role, Apply Online
Natus Medical Market QA Research Role, Apply Online
Post Market Quality Assurance Research
Requisition ID: 12360
Global Function: Quality Assurance
Location: India, Bengaluru
This position is part of the...
What is Clinical Data Management? Complete Guide For Beginners
The field of Healthcare is exponentially evolving at an unprecedented pace, and with this pace, efficient systems to manage the growing volume of clinical...
Sanofi Associate Jobs For Life Sciences, Apply Online
Sanofi Associate Jobs For Life Sciences, Apply Online
Associate Project Specialist-Tiering
Hyderabad, India
Permanent
Posted on: Jan. 22, 2025
Closing on: Mar. 27, 2025
Job title: Associate Project Specialist
Hiring Manager:...
Clinical Data Jobs at IQVIA – Biological Sciences Apply
Clinical Data Jobs at IQVIA - Biological Sciences Apply
Clin Data Spec
Bengaluru, India
Full time
R1447186
Job Description
Job Overview:
Provide basic and some comprehensive data management expertise to the...
PGIMER Research Internship with Monthly Fellowship – Apply Now!
PGIMER Research Internship with Monthly Fellowship - Apply Now!
POSTGRADUATE INSTITUTE OF MEDICAL EDUCATION AND RESEARCH
CHANDIGARH-160 012 (INDIA)
Advanced Pediatrics Center Notice
Dated: 22/01/2025
SERB/VP/2024-5
Applications are invited for...
Biotecnika Times Newsletter 22.01.2025 – Govt Jobs at IPC, Freshers Bioinformatics Vacancies, Summer Internship...
Govt MSc Biotech Jobs at Indian Pharmacopoeia Commission, Apply Now
Explore government job opportunities for MSc Biotech graduates. Apply now!
Freshers CSIR-IGIB Vacancies – Project Job...
Project Research Scientist at MAHE, Manipal – Applications Invited
Project Research Scientist at MAHE, Manipal - Applications Invited
Project Research Scientist-I
The Manipal Academy of Higher Education (MAHE), Manipal invites applications from eligible candidates for...
PGIMER Rs. 65,000 pm Pay Project Research Scientist Job For Life Sciences, Applications Invited
PGIMER Project Research Scientist Job For Life Sciences | Rs. 65,000 pm Pay, Applications Invited
Department of Gastroenterology
Postgraduate Institute of Medical Education and Research
Chandigarh, India
Vacancy...
DBT India Accelerator Grant – Human Frontier Science Program Research Grants Applications Invited
DBT India Accelerator Grant - Human Frontier Science Program Research Grants Applications Invited
DBT India Accelerator Grant - Human Frontier Science Program Research Grants Applications...